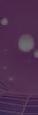

SPAJAMO tehnologiju i ljude










www.imtec.ba Decembar 2022 / Januar 2023












250 G8 • Display: 15,6” • Procesor: Intel Core i3-1115G4 • RAM: 8GB, SSD: 256GB • Garancija: 12 mjeseci 24x46KM 999KM Pavilion Gaming 15-dk2092nm Pavilion 15-eh1038nm • Display: 15,6” • Procesor: AMD Ryzen 5 5500U • RAM: 8GB, SSD: 256GB • Pozadinsko osvjetljenje jjj ProBook 455 G9 • Display: 15,6” • Procesor: AMD Ryzen 5 5625U • RAM: 8GB, SSD: 256GB • OS: Windows 10 Pro • Garancija: 12 mjeseci 24x74KM 1599KM • Intel Core i5-11300H • RAM: 16GB, SSD: 512GB • Grafika: nVidia GeForce GTX 3050 TI (4GB) • Garancija: 36 mjeseci • Cijena: 2199KM, 24x102KM 24x102KM 2199KM 24x55KM 1199KM





















Dell Vostro 5510 • Display: 15.6” • CPU: Intel Core i5-11320H • RAM: 8GB; SSD: 256GB • Garancija: 36 mjeseci 24x76KM 1649KM Vostro 3510 • Display: 15,6”; Procesor: Intel Core i3-1115G4 • RAM: 8GB, SSD: 256GB • OS: Windows 10 Pro • Garancija: 36 mjeseci 24x58KM 1249KM IdeaPad 3 15ITL6 • Display: 15.6” • CPU: Intel Core i5-1135G7 • RAM: 8GB; SSD: 256GB • Garancija: 24 mjeseca 24x53KM 1149KM Flex 5 • Display: 14” Touch; CPU: AMD Ryzen 7 5700U • RAM: 16GB; SSD: 512GB • OS: Windows 11 Pro • Garancija: 24 mjeseca Display:14” Touch;CPU:AMDRyzen75700U 24x97KM 2099KM













Brze performanse za uspješan dan Dell XPS 13 9320 • Display: 13.4” • CPU: Intel Core i5-1240P • RAM: 8GB; SSD: 512GB • Garancija: 36 mjeseci 24x174KM 3759KM Apple MacBook Air 13.3 • Display: 13,3”; CPU: M1 • RAM: 8GB; SSD: 256GB • Garancija: 12 mjeseci 24x58KM 2799KM RAM Memorija za laptope Kingston 32GB DDR5 4800Mhz.............419 KM Kingston 16GB DDR5 4800Mhz.............219 KM Kingston 8GB DDR5 4800Mhz...............119 KM Kingston 16GB DDR4 3200MHz.............149 KM Kingston 8GB DDR4 3200MHz.................79 KM MicroSD 64GB XC Class 10 UHS-I+ad 300S TS - R 95 Mb/s 29KM














































Najbolja podrška za tvoj uspjeh u igri Cloud Core 7.1 Gaming Headset
PC, Xbox Series X|S, Xbox One, PS5, and PS4.
2 godine Alloy Origins 60 AQU mehanička gaming tastatura
2 godine Pulsefire Haste Gaming miš TTC Zlatni mikro otpornici na prašinu. Garancija: 2 godine SoloCast USB mikrofon crni . 6 125KM 89KM 109KM 175KM
Kompatibilnost:
Frekvencjski raspon: 15Hz-25kHz. Garancija:
Kompletno aluminijumsko kućište. Tasteri sa RGB pozadinskim osvetljenjem. 100% anti-ghosting. Garancija:














Imtec Game i3-12100F + AMD RX6400 • Procesor: Intel Core i3 12100F 3,3GHz • Matična ploča: Intel H610M, • RAM: 8 GB DDR4 • SSD: M.2 NVMe 500GB • Grafička karta: AMD Radeon RX6500 4GB DDR6 • Kućište i napajanje: MS Industrial, 400W 80+ Bronze • Garancija: 24 mjeseca. • Veličina ekrana: 27“ • Rezolucija: Full HD 1920 x 1080p • Vrijeme odziva: 7ms • Priključci: VGA, HDMI • Borderless • Garancija: 36 mjeseci AMD RX6400 • Procesor: Intel Core i3 12100F 24x63KM 1349KM AOC 27B2H LED IPS Monitor 12x28KM 299KM Imtec Game Intel Core i5 12400F + Asus nVidia RTX 3050 8GB DDR6 • Procesor: Intel Core i5 12400F 2,5GHz • Matična ploča: Asus B660M-K • RAM: Kingston Beast 3200MHz 16GB DDR4 (2x8) • SSD: M.2 NVMe 500GB • Grafička karta: Asus Dual Force RTX3050 8GB DDR6 • Kućište i napajanje: Asus TUF GT301, Asus 750W 80+Gold • Garancija: 24 mjeseca. 24x123KM 2649KM Asus TUF VG247Q1A LED VA Gaming Monitor • Veličina ekrana: 23,8“ • Rezolucija: Full HD 1920 x 1080p, • Vrijeme odziva: 1ms, • Frekvencija osvježavanja: 165 Hz, • Priključci: HDMIx2, Display port, Audio 2x2W, • Garancija: 36 mjeseci. 12x37KM 399KM

























Imtec Game Intel Core i7 11700F + Asus nVidia RTX 3070 8GB DDR6 • Procesor: Intel Core i7 11700F 2,5GHz • Matična ploča: Asus TUF B560M-PLUS Gaming • RAM: Kingston Beast 3200MHz 32GB DDR4 (2x16) • SSD: M.2 NVMe 500GB • Grafička karta: Asus Dual Force RTX3070 8GB DDR6 • Kućište i napajanje: Asus TUF GT301, Asus 750W 80+Gold • Garancija: 24 mjeseca 24x190KM 4099KM TUF VG277Q1A LED VA Gaming Monitor • Veličina ekrana: 27“ • Rezolucija: Full HD 1920 x 1080p • Vrijeme Odziva: 1ms • Frekvencija osvježavanja: 165 Hz • Priključci: HDMIx2, Display port, Audio 2x2W • Garancija: 36 mjeseci 12x45KM 479KM M.2 NV2 NVMe 3D NAND 1TB..........199 KM; 500GB........119 KM; 250GB.........79 KM Fury BEAST • 16GB DDR4 3200MHz..........165 KM • 8GB DDR4 3200MHz.............75 KM Asus TUF M3 RGB Gaming miš • Optički senzor od 7000 dpi • Aura Sync RGB osvjetljenje. • Garancija: 2 godine 42KM Asus ROG FALCHION wireless mehanička gaming tastatura Osvjetljenje Aura Sync, interaktivna dodirna ploča Cherry MX prekidači. Garancija: 2 godine 209KM BEAST












Ink Tank Wireless 515 + 3 godine garancije • Tehnologija printanja inkjet kolor (sa inktank spremnicima) • Povezivanje printera: USB, WiFi, mreža • Multifunkcijski: Print, copy, scan • Potrošni materijal: HP GT53XL Black Original Ink Bottle (6000 stranica)....25,00KM • HP GT52 (C,M,Y).......22,00KM • Garancija. 1 + 2 godine uz registraciju (sainktankspremnicima)•Povezivanjeprintera:USBWiFimreža 12x33KM 359KM DeskJet Ink Advantage 4828 AiO • DeskJet • Povezivanje: direkt, wireless • Multifunkcijski: Print, copy, scan • Potrošni materijal: HP tinta 6ZD61AE (No.47) Color.......18,00KM HP tinta 6ZD21AE (No.47) Black......20,00KM • Garancija: 1 godina 12x22KM 239KM LaserJet M111a 229KM • Ispis 21 str/min • Funkcije: Ispis • Povezivanje: USB • Koristi toner: 150A (975 str)......99KM














MFP L3250 crni + 3 godine garancije • Tehnologija printanja inkjet kolor (sa inktank spremnicima). • Povezivanje: WiFi Direct. • Multifunkcijski: Print, copy, scan • Potrošni materijal: Epson tinta 103 C,M,Y,K...22,00KM • Garancija: 1+2 godine garancije uz registraciju 12x37KM 399KM MFP Maxify GX6040 + 3 godine garancije • Tehnologija printanja inkjet kolor (sa inktank spremnicima) • Multifunkcijski: printer, skener, kopir, wifi, ethernet + cloud likn. • Povezivanje: USB, mreža, WiFi. • Potrošni materijal: GI46PGBK ZA Maxify Gx6040/Gx7040...85,00KM GI46PGC, M, Y............................................59,00KM • Garancija: 2 + 1 godina uz registraciju 24x50KM 1089KM LaserJet M141A HP toner 150 (W1500A), 975 stranica......99KM 299KM MFP Maxify MB2150 crni + 3 godine garancije Tehnologija printanja inkjet kolor (sa ketridžima) , printer, skener, kopir, faks, WiFi + Could Link Multifunkcijski: printer, skener, fotokopirni uređaj i faks u boji, s podrškom za printanje i skeniranje s mobilnih uređaja i iz cloud-a Povezivanje: WiFi , USB, CLOUD print Potrošni materijal: PGI1500BK crna, PGI1500 cyan, yellow i magenta, Garancija: 2 + 1 godina uz registraciju 12x32KM 349KM • Ispis: 21 str/min, • Funkcije: Ispis, sken, kopir • Povezivanje: USB

Galaxy A13 • Display: 6.6'' PLS LCD. • Procesor: Mediatek MT6769V/ CU Helio G80 Octa-core • Memorija: 64 GB, RAM: 4 GB. • Glavna kamera: quad 50+5+2+ • 2 MP. Prednja kamera: 8 MP. • Garancija 2 godine 12x33KM 359KM Galaxy A53 • Display: 6,5" Super AMOLED 120Hz • Procesor: Exynos 1280 (5 nm), Octa-core • Memorija: 128GB, RAM: 6GB • Glavna kamera: 64MP, 12MP, 5MP, 5MP • Prednja kamera: 32MP, 4K • Garancija: 2 godine 24x37KM 799KM Redmi Note 11 • Display: 6,43''AMOLED, 90Hz • Procesor: Snapdragon 680 (6 nm), Octa-Core • Memorija: 64GB, RAM: 4GB • Glavna kamera: 50 MP+ 8 MP+ 2 MP + 2MP • Prednja: 13 MP • Garancija: 2 godine 12x42KM 339KM Galaxy Tab A7 Lite T220 • Display: 8,7" TFT • Procesor: Octa-core • Memorija 32GB. RAM: 3GB • Kamera: prednja: 8 MP, zadnja: 2MP • Garancija: 24 mjeseca 12x29KM 315KM


















Ne brini da ćeš nešto propustiti Galaxy Tab A8 2021 SM-X200 • Display: 10,5" TFT. • Procesor:Octa-core; Unisoc Tiger T618 (12 nm). • Memorija: 64GB, RAM: 4 GB. • Kamera: prednja: 5 MP, zadnja:8MP. • Garancija: 24 mjeseca. 12x23KM 499KM Galaxy Watch5 Pro 45mm BT • Ekran: 1,4'', Sapphire crystal • Procesor: Exynos W920 (5 nm) • Akcelerometar, žiroskop, puls, barometar, termometar (tjelesna temperatura) 24x63KM 749KM , Galaxy buds 2 PRO • Razgovor: 14 hr. Wireless/bluetooth • Bluetooth 5.3 • Mikrofon: da. Boje: bijela, purple i graphite • Garancija: 1 godina 12x34KM 369KM Samsung punjač EP-T4510XBEGEU Tyoe C 45W 79KM Canyon power bank CNS-CPB1001W 10000mAh 59KM














Smartwatch CNE-KW31BB Tony Kids • Display: 1,54". Interfejs i stil prilagođen djeci. • Ne zahtijeva vezu sa pametnim telefonom. • GSM telefonska komunikacija za 2G standard, dvosmjerni pozivi. • Dimenzije: 54 x 42,6 x 13,6 mm. Težina: 42gr. • Garancija
godina. 65KM smartwach P28 Plus zlatni • 1,69’’, rezolucija ekrana 240x280, • Baterija 190 mAh, • CPU: GR5515 • Nivo vodootpornosti: IP67, • Brojčanici sata: Dinamički brojčanik, tržište brojčanika sata i DIY brojčanik sata • Garancija 12 mjeseci. 79KM Smartwatch AmazFit GTS 2 Mini, pink
Ultra tanak,
vodotoporan i uvijek uključen AMOLED
Trajanje
do 21 dan
zasićenosti krvi
• 70+ sportskih
Alexa
149KM Bluetooth zvučnik BHR4802GL Otporan na vodu i prašinu 2000mAh 49KM MC MicroSD 128GB UHS-I U3, SDCG3/128GB 59KM Mini veličina, maksimalna snaga
1
• Ekran: 1,55".
lagan dizajn,
ekran. •
baterije
• Mjerenje
kisikom,
načina,
ugrađena • Težina samo 19,5 g. • Garancija 2 godine.






























EOS R10 Body 24x91KM 1969KM EOS 6D Mark II Body 24x125KM 2699KM EOS RP Body 24x97KM 2099KM EOS R6 Body 24x243KM 5249KM EOS M50 Mark II 15-45 24x67KM 1449KM Senzor: APS-C Video: 4K 60p YouTube live streaming Senzor: FullFrame Baterija: 250 snimaka Garancija: 24 mjeseca Senzor: FullFrame Fokus: 45 AF tačaka Baterija: 1200 snimaka Stabilizacija: 5-osni system AF: Tijelo, Lice, Oči, Životinje Brzina okidanja: 12 fps Senzor: APS-C s 24.1 MP Ulaz za vanjski mikrofon od 3.5mm YouTube live streaming






















Z50 + 16-50mm VR 24x97KM 2099KM Nikon Z6 II Body 24x166KM 3599KM Alpha a7 Mark IV 28-70 24x278KM 5999KM Alpha a6000 16-50mm 24x55KM 1199KM Senzor: APS-C DX Brzina okidanja: 11 fps Baterija: 300 snimaka Senzor: FullFrame FX Pohrana: 2x slot Fokus: 273 tačke AF Senzor: APS-C, Fokus: 179 tačaka Brzina okidanja: 11 fps 33MP Video: 4K 60p/4:2:2 10bit Stabilizacija: 5-osni sistem























Hero11 Black 24x58KM 1249KM Hero9 Black 24x42KM 899KM DJI Mini 3 Pro 24x83KM 1799KM DJI RS 3 Combo Gimbal OLED 24x71KM 1539KM



























Gran Tursmo 7 standard Ed + Destruction AllStars PS5 Playstation 5 sa optičkim uređajem + 2 igre 24x72KM 1559KM Volan G29 Volan, pedale, adapter, uputstvo. 900 stepeni lock to lock rotacija, nelinearna kočna pedala. Vibracija: Dual-Motor Force Feedback Povezivanje: USB 2.0, Podržava PC / PS4 / PS3. Garancija 2 godine. 12x74KM 799KM Trust stolica GXT 708 plava 12x33KM 359KM Vo 90 ko Vi Po Ga M X-trike stolica GC-909 game zelena 12x29KM 315KM






Vivax klima R-Design Inverter ACP-12CH35AERI+ A+++/A++ klasa -25ºC •
•
•
•
•
•
24x56KM 1199KM Tesla konvektor PC250WH 2500W • Kontrola temperature •
•
•
•
129KM GREE
Lomo Regular inverter GWH12ACC-K6DNA3I Wi-Fi,
•
•
•
•
24x62KM
Kapacitet hlađenja / grijanja: 3,51kW/ 3,81kW.
Energetska klasa hlađenje / grijanje: A+++ / A++
Plin R32. Namijenjena za površine do 45 m2
Područje rada: -25 do 50 stepeni C.
Protok zraka: do 584m3/h
Garancija 5 godina uz redovan godišnji servis.
Dvije opcije: 1250W/2500W
Mogučnost montaže na zid
Boja: bijela
Zagrijava prosječno 20-30 m2 unutrašnjeg prostora. • Garancija: 1 godina
klima
R32
Učinak grijanja 3,67(0,60-5,13)kW, hlađenja 3,5(0,70-4,0)kW.
Za prostorije do 45m2. Wi-Fi integrisan
Grijanje i hlađenje pri vanjskoj temperaturi -22 do 43 C.
Garancija 3 godine uz redovan godišnji sevis.
1329KM
• Veličina: 75'' 190 cm




• Vrsta: Android 11 • Rezolucija: 3840x2160 Ultra HD • Posebne specifikacije: WiFi, Bluetooth, Satelitski S2 prijamnik, DVB-T2/C/S2. 24x83KM 1799KM









OLED 55OLED807/12
+ Soundbar
55''
• TAB8405/10 • Veličina ekrana: 55 '' 140 cm • Vrsta: Android TV™ 11 (R) • Rezolucija: 3840 x 2160 4K Ultra HD OLED • Posebne specifikacije: Ambilight TV s 4 strane • Dolby Atmos zvuk. 120 Hz • DVB-T/T2/T2-HD/C/S/S2 • Garancija: 2 godine 24x134KM 2899KM LED KD55X89JAEP + 5 godina garancije • Veličina ekrana: 55'' 140 c • Vrsta: Google TV • Rezolucija: 3840 x 2160 4K Ultra HD • Posebne specifikacije: Google TV HDR procesor X1 Triluminos HDMI 2.1 panel 120HZ. • Garancija: 2+3 godine uz vaučer prilikom kupovine 24x69KM 1499KM Vivax LED 75UHD10K + 5 godina garancije

















LED UE50AU7022 50'' + 5 godina garancije • Veličina: 50'' 127 cm • Vrsta: smart OS Tizen • Rezolucija: 3840×2160 • Posebne specifikacije: LED, DVB-T2C, Smart, UHD Dimming, Crystal Processor 4K, Sound Output (RMS): 20W, Bluetooth, Wifi, HDMI A / Return Ch • Support, VESA 200 x 200 mm, PQI 2000, 3 x HDMI, 1 x USB, eARC. • Garancija: 2 + 3 godine uz vaučer prilikom kupovine 24x37KM 799KM Tesla LED 40E320BF • Veličina: 40'' 100 cm • Vrsta: bazni hotel mode • Rezolucija: 1920×1080 • Posebne specifikacije: Ugao gledanja: 178°/178° • Jačina zvučnika: 2x10W; Povezivanje: 3XHDMI, 2XUSB, RF Input, LNB Input, AV Composite, PC Audio, VGA, CI+, HeadPhones, Digitalni audio izlaz; PVR, Sleep Timer, Hotel Mode, Noise Reduction; DVB-T/T2/C/S/S2. • Garancija: 3 godine 12x33KM 359KM 12x30KM 329KM Vivax LED 32LE20K K • Rezolucija: 1366 X 768 (HD) • OS: Android 11 • DVB-T2/C/S2 • Garancija: 2 god















Svjež i čist zrak u tvom domu Prečišćivač zraka AIR 6 MAX • Pokriva do 48m2 • Garancija: 2 godine 24x37KM 399KM Mi prečišćivač vazduha 4 Lite sa HEPA filterom
Štiti
mirisi.
2 godine 12x27KM 289KM Prečišćivač zraka LV-H132XR+ ekstra filter Pre-filter, HEPA Filter, filter sa aktivnim ugljem. Indikator provjere filtera: da. Indikatori kvalitete zraka: ne. Noćni način rada Sleep mode: da. Timer: 2/4/8 sati. Primjenjiva površina: do 12m2. Garancija: 2 godine 185KM Mi robot Mop 2 Pro bijeli BHR5044EU Mi Robot usisvač Mop 2 Pro bijeli, 5200mAh baterija, usisna snaga 3000 Pa. Garancija: 1 godina 24x37KM 799KM
Pokriva: 43m2. Wifi: da. Troslojna filtracija za zrak.
od: dlake kućnih ljubimaca, polen, prašina, dim, perut, pamučna vlakna. mirisi, isparavanja od kuhanja, VOC, formaldehid, toluen i ostali
Garancija:





Jasan pogled na sve što se događa u tvom domu DAP-1325 Wireless N Range Extender 42KM MESH Wi-Fi sistem COVR-1102/E 179KM IP FullHD kamera DCS-6500LH/E 69KM Full HD Outdoor Wi-Fi Camera DCS-8600LH/E 89KM







• Tower, 2-bays • 2x 3.5-inch SATA 6Gb/s, 3Gb/s • ARM 4-core Cortex-A55 2.0GHz procesor • RAM 2GB • Gigabit Ethernet Port (RJ45) • 1x USB 3.2 • 2x USB 2.0 575KM Napravi svoj privatni Cloud i kopiraj datoteke sa svojih uređaja Dijelite i sinhronizujte datoteke sa drugim ljudima i uređajima NAS storage Qnap NAS storage TS-233 UPS CP900EPFCLCD • Linijska interaktivna topologija • Zaštita od prenapona • Izlaz čiste sinusoide • Zaštita telefona/faksa/modema/DSL-a/mreže VA 900 Watts 540 Izlazni napon ( Vac ) 230 ± 10% Vrijeme rada pri pola opterećenja ( min ) 7 Izlazi Šuko x 6 449KM
Interaktivni set za učenje


Smart tabla dijagonale 77“ sa širokokutim projektorom Birajte boje, sadržaje, dijelite lekcije s drugima ma gdje bili. Uključen i Smart softver, dvije olovke i nosači.





Projektor X1529H Full HD
16:9
1399KM Projekcijsko platno na stalku 180cm x 180cm 209KM Mobilni stalak za projektor i laptop 159KM
Učenje bez ograničenja!
• Osvjetljenje 4500 lumena. Omjer
• Trajanje lampe do 20.000h • Povezivanje: VGA, HDMI, USB. Zvučnici
3999KM
IMTEC PJ ARIA
Trg djece Sarajeva 1. Mob/Viber 062 809 228
IMTEC PJ ZENICA
Maršala Tita 2 Mob/Viber 062 807 825
IMTEC PJ ILIJAŠ
Bosanski put bb, (u blizini autobuske stanice) Mob/Viber 062 806 898
IMTEC PJ SCC
Vrbanja 1. Mob/Viber 062 809 171

IMTEC PJ MOSTAR
Stjepana Radića bb Mob/Viber 062 807 342
IMTEC PJ Dobrinja Nurije Pozderca 5. (Bulevar branilaca Dobrinje) Mob/Viber 062 808 269
IMTEC PJ TUZLA Univerzitetska 16, RK TUZLANKA Mob/Viber 062 806 118
IMTEC PJ Ilidža
Butmirska cesta 14 (TC Grand centar) Mob/Viber 062 808 032

IMTEC PJ TEŠANJ
Bukva bb (TC UKUS) Mob/Viber 062 807 352
IMTEC PJ VISOKO
Branilaca bb (TC Suša) Mob/Viber 062 807 446
IMTEC PJ KAKANJ
Alije Izetbegovića 37. Mob/Viber 062 807 354
IMTEC PJ GORAŽDE
Trg Branilaca bb Mob/Viber 062 806 735
Cijene? Cijene su maloprodajne sa popustom 10%, kao i iskazanom visinom mjesečne rate sa uračunatim PDV-om, bez dodatnih popusta. Opis? Navedene specifikacije i prikazane fotografije artikala su informativnog karaktera, te su moguće greške na kojima se unaprijed izvinjavamo. Isporuka? Omogućili smo besplatnu isporuku na teritoriji BiH za narudžbe preko 150 KM. Posjetite naš webshop www.imtec.ba Kupovina na rate? Imate redovna mjesečna primanja i trebate kupovinu na rate? Nudimo Vam kupovinu na 12 rata, bez obzira da li ste u stalnom radnom odnosu. Za više informacija posjetite ili pozovite najbližu IMTEC poslovnicu.


www.imtec.ba
































































































































































































































































































































































































